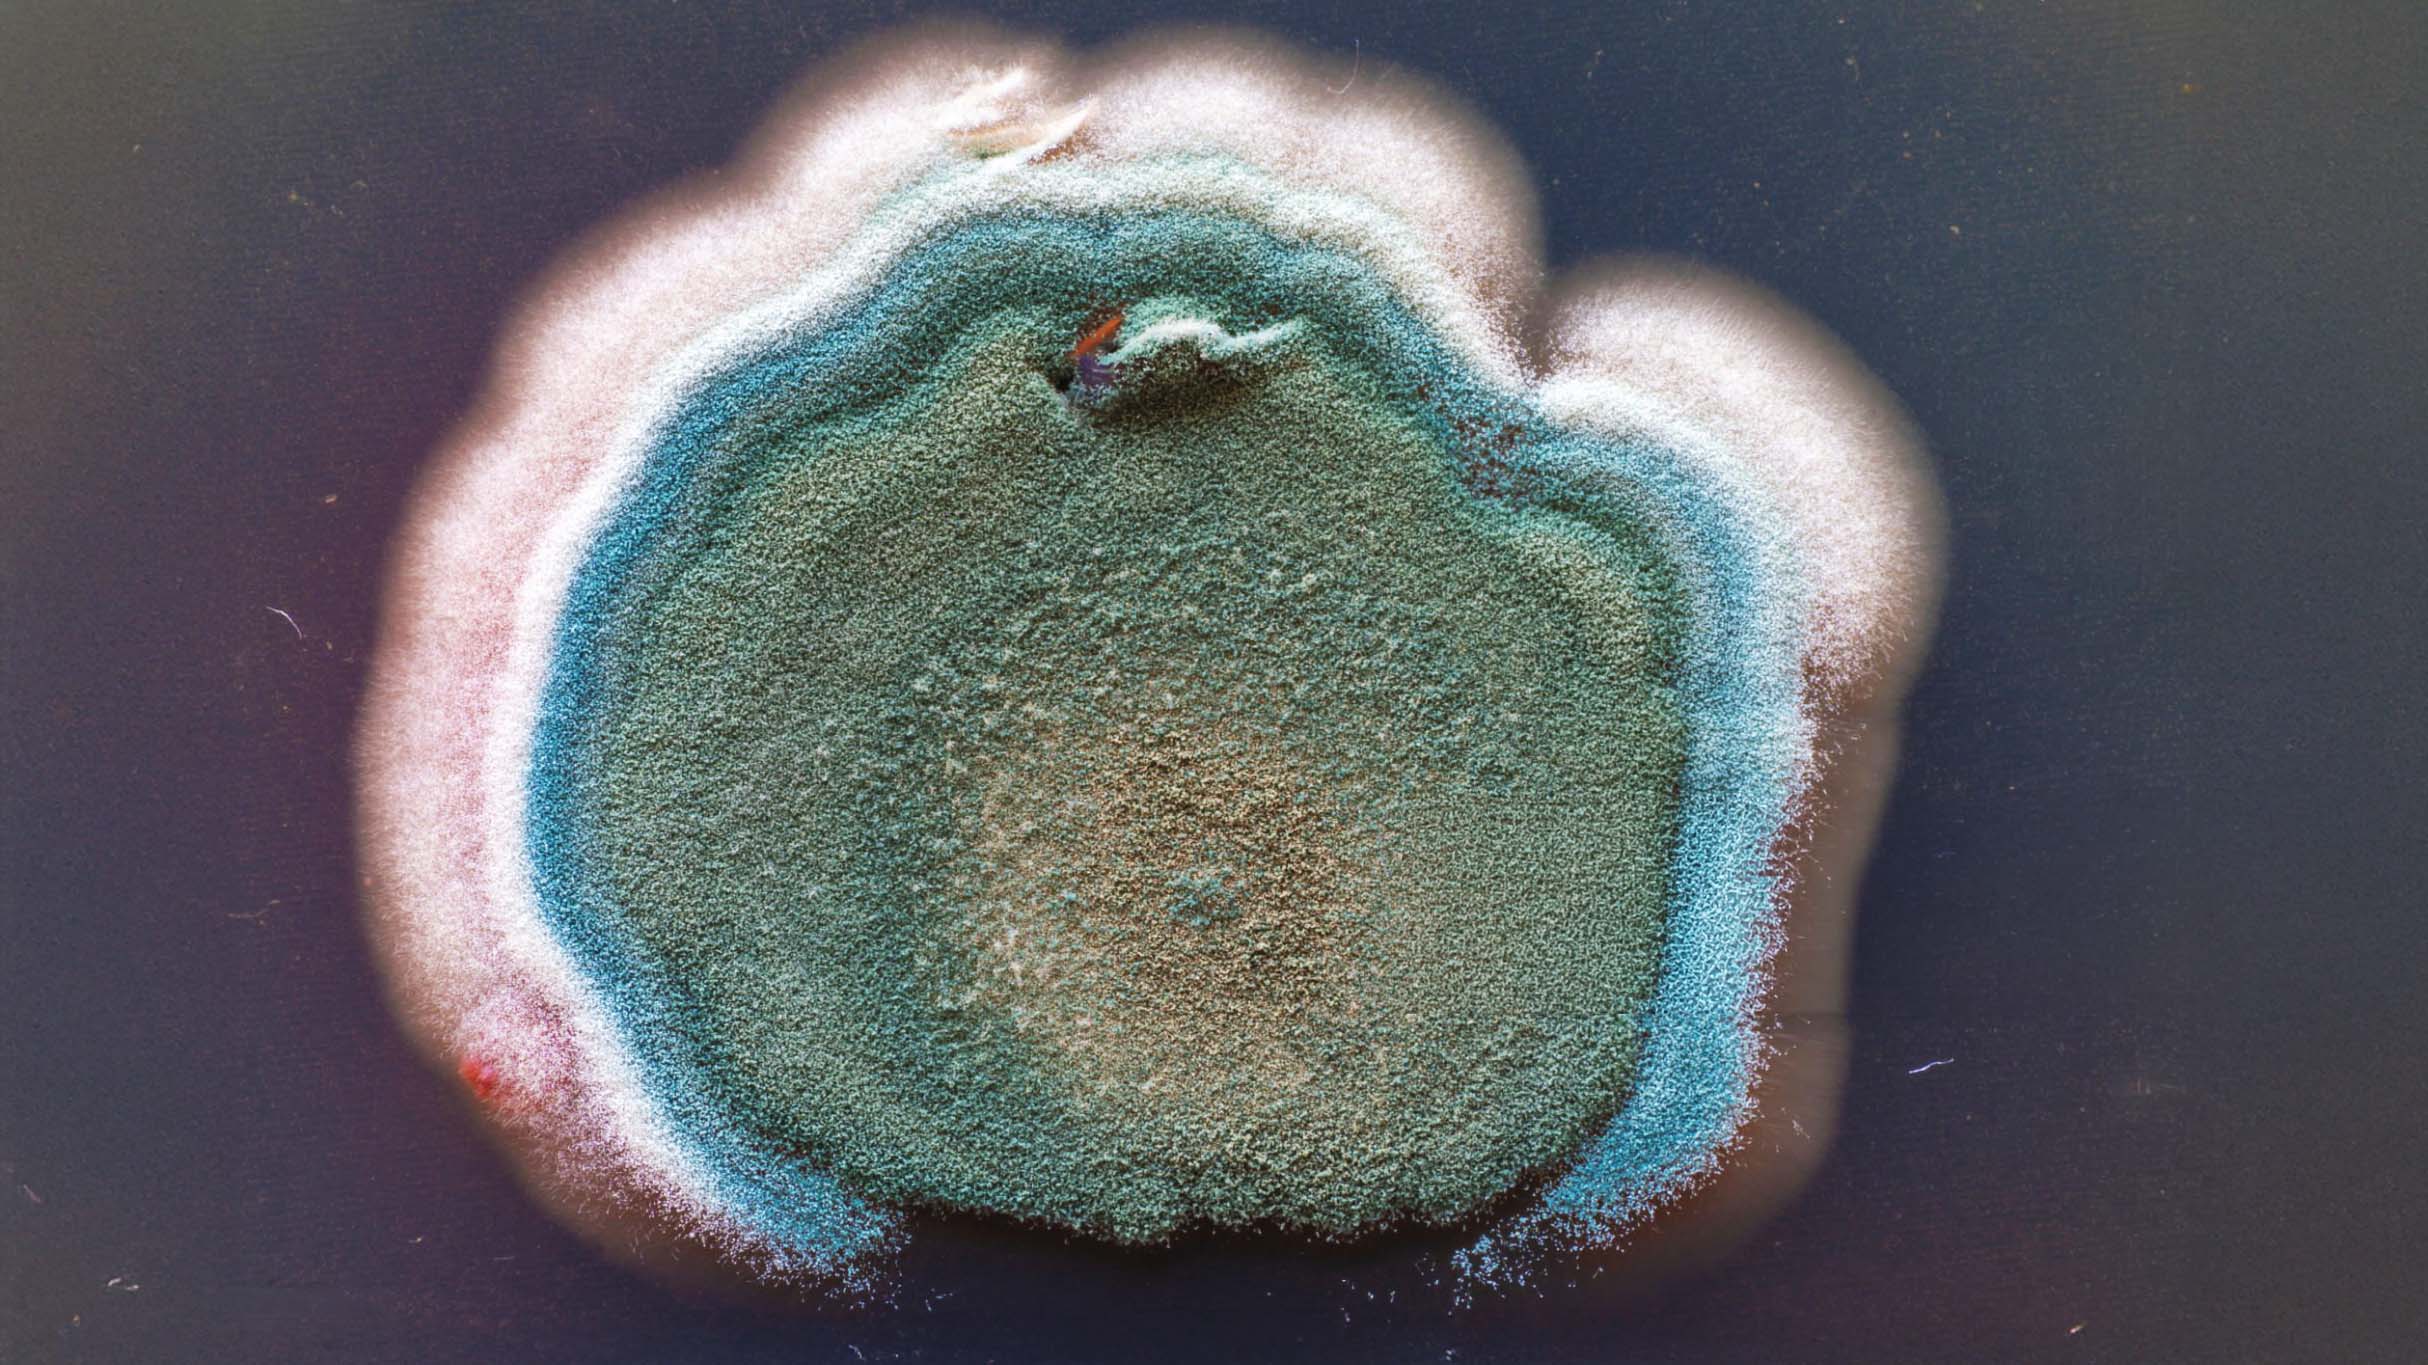

Seppic
2023


INSIGHT
INSIGHT
A molecule without a mission is just a commodity
As the industry scales, the human element, the reason why we innovate, is frequently lost in the clinical data.
An industrial supplier provides a product, a partner provides a future.
In an era of rapid transformation, technical excellence is no longer enough to lead
A molecule without a mission is just a commodity
As the industry scales, the human element, the reason why we innovate, is frequently lost in the clinical data.
An industrial supplier provides a product, a partner provides a future.
In an era of rapid transformation, technical excellence is no longer enough to lead
IDEA
IDEA
Science that cares
We evolved Seppic from a silent ingredient supplier into a strategic visionary.
By bridging the gap between laboratory excellence and human well-being, we proved that the most powerful formulas are built on a foundation of care.
Science that cares
We evolved Seppic from a silent ingredient supplier into a strategic visionary.
By bridging the gap between laboratory excellence and human well-being, we proved that the most powerful formulas are built on a foundation of care.









STUDIO
Cenitz Studio
Credits
Julien Tardif
Creative Director
Studio
Cenitz Studio
Credits
Julien Tardif
Creative Director